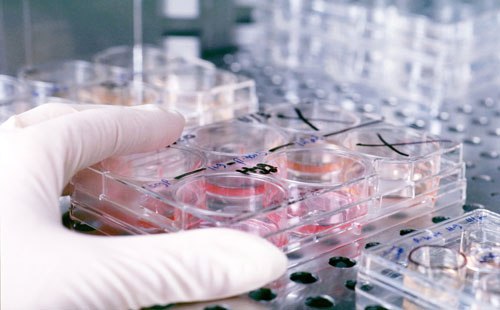
علماء يطورون مضادا حيويا يقتل البكتريا دون مقاومة

اكتشف العلماء نوعا جديدا من المضادات الحيوية يستطيع القضاء على العدوى الخطيرة التي تصيب الفئران دون أي مقاومة ملحوظة وذلك في تطور من شأنه أن يكون فتحا جديدا في جهود مكافحة الجراثيم التي تطور نفسها.
وقال الباحثون إن عقار تيكسوباكتين الذي لم يجرب بعد على البشر قد ينجح في يوم ما في معالجة أنواع عدوى مقاومة للعقاقير مثل بكتيريا إم.إس.آر.إيه والسل الذي يستلزم علاجه توفير مجموعة من العقاقير لها آثار جانبية وخيمة.
وقال كيم لويس الأستاذ في جامعة نورث إيسترن الأمريكية والمؤسس المشارك لشركة نوفوبايوتك للعقاقير الطبية صاحبة براءة اختراع تيكسوباكتين "إن اكتشاف هذا المركب الجديد يمثل تحديا لمعتقدات علمية قائمة منذ فترة طويلة ويقدم أملا كبيرا في علاج مجموعة من أنواع العدوى الخطيرة."